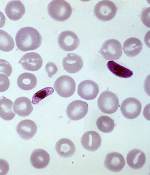

Rajasthan 
Photonic Crystal to Diagnose Malaria
(1)Diagnosing malaria is difficult because there are different Plasmodium species producing wide variations in symptoms. And blood smear test often gives false negatives. Researchers from three colleges in Bikaner have now come up with a new faster and more accurate, diagnostic tool.
A Concrete Deal: Using rubber waste
Acids eat into cement, making concrete weaker. MNIT, Jaipur overcomes the problem with crumbs from waste tyres.
Copper Oxide Nanoparticles: synthesis with neem leaf extract
Producing nanomaterials, using plant extracts, is emerging as a promising approach to create metal oxide nanoparticles with potential applications in optoelectronics, nanosensors, nanodevices, nanoelectronics, information storage, and catalysis. Among the various metal oxide nanoparticles, copper nanoparticles are of great interest, because of their low cost of preparation and excellent physical and chemical properties. Copper nanoparticles… Read More ›